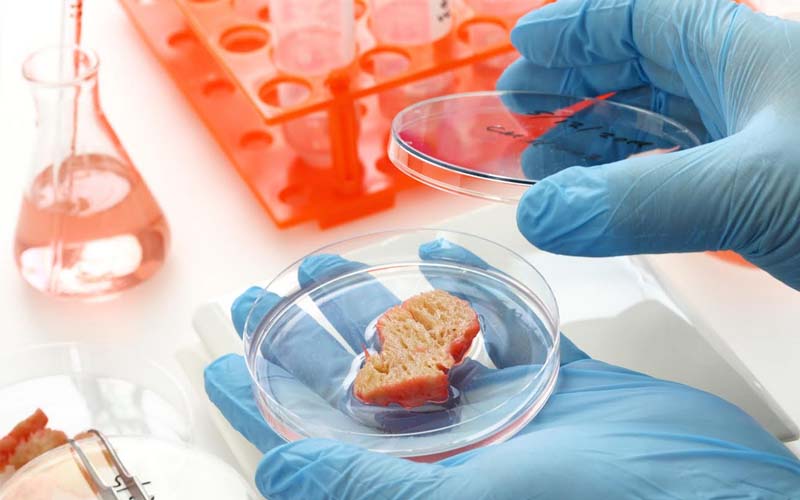

Агенцията за стандартизация на храните (FSA) проучва начини за ускоряване на процеса на одобрение на храни, отгледани в лаборатория, известни като продукти от култивирани клетки (CCP), като целта е през следващите две години да бъдат завършени оценките за безопасност на два такива продукта.
За участие в регулаторния „пясъчник“ на агенцията са избрани осем компании, които представят разнообразни международни експертни познания. Базираните в Обединеното кралство Hoxton Farms, Roslin Technologies и Uncommon Bio ще си сътрудничат със световни фирми, сред които BlueNalu (САЩ), Mosa Meat (Нидерландия), Gourmey (Франция), Vital Meat (Франция) и Vow (Австралия).
През октомври FSA получи финансиране в размер на 1,6 млн. паунда от правителствения фонд Engineering Biology Sandbox Fund (EBSF), за да стартира иновативна програма за пясъчници за ЦК. Това финансиране ще спомогне за по-нататъшното разработване на регулаторната рамка за тези продукти и ще ускори пътя им към пазара.
Професор Робин Мей, главен научен съветник във FSA, подчерта, че безопасността на потребителите ще остане от първостепенно значение по време на процеса.
Професор Мей коментира:
Безопасните иновации са в основата на тази програма. Като даваме приоритет на безопасността на потребителите и се уверяваме, че новите храни, като ХВП, са безопасни, можем да подкрепим растежа в иновативните сектори. Нашата цел е в крайна сметка да предоставим на потребителите по-широк избор от нови храни, като същевременно запазим най-високите стандарти за безопасност.“
През 2020 г. Сингапур става първата държава, която разрешава продажбата на месо от клетъчни култури за консумация от човека, последвана от САЩ през 2023 г. и Израел през 2024 г.
Въпреки това, макар Обединеното кралство да играе ключова роля в развитието на науката за лабораторно отглежданите храни, то се сблъсква със забавяния в търговската реализация на тези продукти поради регулаторни пречки. С усъвършенстването на процеса на одобрение FSA се надява да позиционира Обединеното кралство като лидер в този нововъзникващ сектор.
Домашните любимци опитват първи
Докато лабораторно отглежданите храни за хора все още не са достигнали до рафтовете на магазините в Обединеното кралство, култивираното месо вече е достъпно за домашните любимци. Миналия месец британската фирма Meatly пусна на пазара „Chick Bites“ - лакомства за кучета, съчетаващи растителни съставки с култивирано пилешко месо - в сътрудничество с марката за растителна храна за кучета THE PACK. Продуктът дебютира в Pets at Home в Брентфорд, Лондон, отбелязвайки първата продажба на дребно на култивирано месо в Обединеното кралство.
Процесът на Meatly включва отглеждането на пилешко месо от една проба клетки, взети от яйце, като по този начин се произвежда устойчив източник на храна без клане на животни.
Тъй като FSA работи за ускоряване на регулаторната рамка, хранителната индустрия в Обединеното кралство е изправена пред значителна промяна. При успех лабораторно отглежданите храни биха могли да предоставят на потребителите по-безопасен и по-екологичен избор, като в същото време укрепват репутацията на страната в областта на хранителните иновации.

